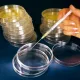
Einmal Kunststoff Petrischalen, ohne Nocken, unsteril, drm. 90 mm (480 Stück)

Suchen
Einstellungen
Einstellungen
Versandland
Währungen
Menü
StartseiteLaborbedarfLabor-Zubehör-Mikroskopie-BedarfEinmal Kunststoff Petrischalen, ohne Nocken, unsteril, drm. 90 mm (480 Stück)

Einmal Kunststoff Petrischalen, ohne Nocken, unsteril, 90 mm drm. (480 Stück)
Einmal Kunststoff Petrischalen, ohne Nocken, unsteril. Spitzenqualität, komplett mit Deckel, unsteril, glasklar, automatengeeignet, Ø 90 mm, Höhe 16 mm.
Zuletzt angesehen
Kontakt
CLS Medizintechnik und Vertrieb
Inh. Claudia Scholz
Gross Thiershausen 2
37434 Krebeck-Renshausen
Inh. Claudia Scholz
Gross Thiershausen 2
37434 Krebeck-Renshausen
Informationen
Zahlungsarten
Alle Preise inkl. gesetzl. MwSt. zzgl. Versandkosten. Die durchgestrichenen Preise entsprechen dem bisherigen Preis bei Alles für die Arztpraxis.
Alles für die Arztpraxis © 2026 | Template © 2009-2026 by modified eCommerce Shopsoftware
Alles für die Arztpraxis © 2026 | Template © 2009-2026 by modified eCommerce Shopsoftware
- Restposten + Schnäppchen
- Praxisbedarf
- Akupunktur / Naturheilkunde
- Laborbedarf
- Injektion und Infusion
- Desinfektion und Reinigung
- Chirurgische Instrumente
- Sterilisation und Aufbereitung
- Nahtmaterial und Wundverschluß
- OP-Bedarf
- Verbandstoffe
- Tattoo-und Piercing-Bedarf
- Medizinische Geräte
- Medizinische Möbel
- Patienten-Pflegebedarf
- Erste Hilfe & Notfall
- Anaesthesie
- Hersteller
- 3M Health Care
- Abbott GmbH
- Acufirm
- AGA Sanitätsartikel GmbH
- Akra Dermojet
- Almedica
- AMBU GmbH
- Amefa
- Amor Gummiwaren GmbH
- Amsino Healthcare inc.
- Applimed
- Arkray Inc.
- ASAM Betriebs-GmbH
- asiamed
- Aspen Surgical Products Inc.
- Atmos
- B.Braun SE
- B.Braun SE / Aesculap
- BAG Health Care
- Baxter Deutschland GmbH
- BD, Becton Dickinson GmbH
- Berrcom Guangzhou
- Beurer
- BGT BioGenTechnologies GmbH
- Bisanz Medizinische Polster GmbH
- BODE Chemie GmbH & Co. KG
- Boettger
- Bollmann by Pull UP
- Bosch und Sohn GmbH & Co.KG
- BOWA
- Brand
- BrAun Healthcare
- Browne Steris SAS
- BSN medical - Essity
- Bühler-Instrumente Medizintechnik GmbH
- C.Bruno Bayha GmbH
- C+V Pharma
- Care & serve
- Caromed
- CBC Christophorus
- Cedip
- Centramed
- Choice MMed
- Clap Tzu
- Clinhand Samco
- CLINICAL
- Cloud & Dragon
- Comed SAS
- Covidien
- Creative Medical
- Credo Solingen
- Derungs medical GmbH
- Diaglobal
- Diagonal
- Diagramm Halbach
- DISPOMED GmbH & Co. KG
- Dongbang
- Dr. Paul Koch GmbH
- Dr.Deppe
- Dr.Junghans
- Dr.Mach
- Dr.Schumacher
- Dr.Weigert
- Droh
- Durable
- Dürasol
- Ecolab
- EKASTU
- Elite Bags
- EMIL DEISS KG (GmbH + Co.)
- Epredia Netherlands B.V.
- ERBE
- Erler-Zimmer GmbH & Co.KG
- ERMIS MedTech GmbH
- Ethicon
- Euronda Deutschland GmbH
- FIAB Spa
- Fisher Scientific GmbH
- Fresenius Kabi Deutschland GmbH
- Gello GmbH
- Georg Schmerler Schutzbrillen- u. optische Fabrik GmbH & Co. KG
- Glaswarenfabrik Karl Hecht GmbH & Co KG
- GlaxoSmithKline GmbH & Co. KG
- Golmed GmbH
- GRAMM medical healthcare GmbH
- Greiner GmbH
- HAEBERLE GmbH + Co. KG
- HEBU medical GmbH
- Heine Optotechnik GmbH
- Heinz Herenz Medizinbedarf GmbH
- Helmut Schwarz GmbH
- HGV Verbandstoffe GmbH
- HIMED medical products GmbH
- Hitado
- Holthaus Gmbh & Co.KG
- HUDSON RCI
- HUM Gesellschaft für Homecare und Medizintechnik mbH
- Huntleigh Healthcare GmbH
- Hupfer Metallwerke GmbH & Co. KG
- HYGOSTAR
- Infumed GmbH
- Intersurgical GmbH
- Jäger
- KAI Europe GmbH
- Kern & Sohn GmbH
- Kiato/Medimex
- KIRCHNER & WILHELM GmbH + Co. KG
- KLS Martin SE & Co. KG
- Leina werke GmbH
- Lockweiler Plastic Werke GmbH
- Lohmann & Rauscher GmbH & Co. KG
- LUXAMED GmbH & CO. KG
- Magrain
- Maimed GmbH
- Mank GmbH
- mauser einrichtungssysteme GmbH & Co. KG
- Medi-Pack GmbH
- Medical Econet
- Medicoplast International GmbH
- medimex GmbH
- Medinorm Medizintechnik GmbH
- Meditech Produktions GmbH
- Meditrade
- Megro GmbH & Co.KG
- MELAG Medizintechnik GmbH & Co. KG
- Merck Chemicals
- Meridius Medical GmbH
- Mesics GmbH
- Mitsubishi
- ms Praxistextilien
- Mühlacker Metallwaren
- Nitras
- notfallkoffer.de Med. Geräte GmbH
- Nutriplate GmbH
- OCULUS Optikgeräte GmbH
- Ophardt Hygienesysteme
- OraSure Technologies Inc.
- Osram GmbH
- Owen Mumford GmbH
- Parker Laboratories BV
- Paul Hartmann AG
- Paul Marienfeld GmbH & Co.KG.
- Pemax Kunststoff GmbH
- PFM medical gmbh
- PRÄMETA GmbH und Co. KG
- Primed Halberstadt Medizintechnik GmbH
- Promeditech GmbH
- provita medical gmbh & co. kg
- QUESTALPHA GmbH & Co. KG
- Ratiomed
- Redam Instrumente GmbH
- Reger Medizintechnik GmbH
- rego gmbh
- RK Instruments
- RND sportive
- Roche Diagnostik
- Rudolf Riester GmbH
- Sakamura
- Sano-Trend Orthoservice GmbH
- SARSTEDT AG & Co. KG
- SCHMITZ medical GmbH
- Schülke & Mayr GmbH
- SCHÜRR Schuhvertrieb GmbH
- Sedatelec SASU
- SEIRIN Corporation
- Sengewald Klinikprodukte GmbH
- SERAG-WIESSNER GmbH & Co. KG
- Servoprax GmbH
- Shenzhen Creative Industry Co.Ltd.
- Siemens Healthineers AG
- Sigmapharm Arzneimittel GmbH
- SIMPEX GmbH
- SL Akupunktur GmbH
- Smith & Nephew GmbH
- Smiths Medical Deutschland GmbH
- Sony Deutschland GmbH
- Speziallampenfabrik DR. FISCHER GmbH
- Stericop GmbH & Co. KG
- STERIS Deutschland GmbH
- Sterisets Medical Products
- SteriTec Meb.o. Gettinge Group
- Swann-Morton Limited
- TattooMed GmbH
- TEE-UU
- Traderia GmbH
- Uhumed
- ultraMEDIC GmbH & Co. KG
- Unigloves
- Valentine International Ltd
- VBM Medizintechnik GmbH
- Vitalograph GmbH
- VP Stericlin
- WACA-Kunststoffwarenfabrik Heinrich Walch GmbH + Co. KG
- Waldeck GmbH & Co. KG
- WEINMANN Emergency Medical Technology GmbH + Co. KG
- Wieds Ecochem AG
- Wilkinson Sword GmbH
- Wipak Walsrode GmbH
- WMC Medical Consulting Group GmbH
- Zellamed
- Zepf medical instruments GmbH



